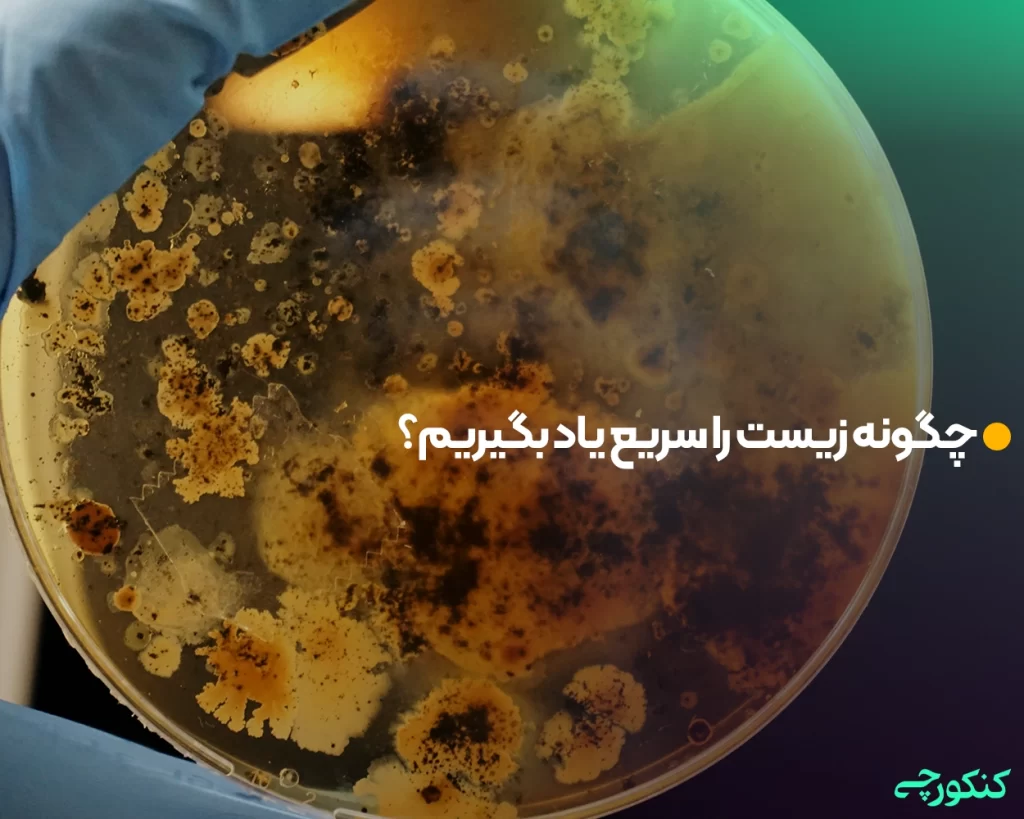
چگونه زیست را شب امتحان بخوانیم؟

زیست شناسی از مهمترین درسهای رشته تجربی است. گرفتن نمره بالا در این درس در معدل دانشآموزان تاثیر مثبتی دارد و با توجه به تاثیر معدل در کنکور، داوطلبان میتوانند رتبه بهتری کسب کنند. همچنین ضریب درس زیست شناسی در کنکور 12 است و این درس بیشتر از دروس دیگر در نمره و تراز داوطلب موثر است. بنابراین روش خواندن زیست و یادگیری بهتر این درس اهمیت ویژهای دارد. متاسفانه گاهی دانشآموزان به خاطر استرس یا عدم آگاهی از شیوههای صحیح مطالعه درس زیست شناسی نمیتوانند عملکرد خوبی در جلسه امتحان داشته باشند. اما چگونه میتوان زیست را بهتر خواند و مفاهیم آن را برای مدت زمان طولانیتری به خاطر سپرد؟ در ادامه ما روشها و تکنیکهایی را برای خواندن درس زیست شناسی آماده کردهایم که با استفاده از آنها میتوانید نتیجه دلخواه خود را در امتحان و کنکور به دست بیاورید.
چگونه زیست بخوانیم؟
با توجه به این که کتاب زیست شناسی دارای ماهیت حفظی و مفهومی است پیشنهاد میکنیم برای یادگیری بهتر این درس ابتدا آن را پیشخوانی کنید و سپس مباحث را با تکرار و تمرین به طور کامل یاد بگیرید. بعد به سراغ منابع آموزشی دیگر بروید و آنها را مطالعه کنید. توجه داشته باشید که در درس زیست شناسی باید تمامی مطالب کتاب درسی را به طور کامل یاد بگیرید و سپس به سراغ تستزنی بروید. بهتر است ابتدا تستهای آسانتر را انتخاب کنید و نکات مهم هر تست را در برگهای جداگانه یادداشت کنید. به طور کلی درس زیست باید به شکل حفظی، مفهومی و ترکیبی مطالعه شود. در صورتی که روی فصلهای اول کتاب کاملا تسلط داشته باشید مطالعه فصلهای بعد راحتتر میشود. فراموش نکنید که نکات مهم هر فصل را به صورت مجزا از دیگر فصول بررسی کنید.
برای مطالعه مفهومی درس زیست به نکات زیر توجه کنید:
- مطالب مهم را خلاصه نویسی کنید.
- تستهای تالیفی و تستهای کنکور را حل کنید.
- زمان بیشتری را به نقاط ضعف خود اختصاص دهید تا آنها را برطرف کنید.
- مباحث را پس از یادگیری کامل برای خودتان توضیح دهید.
- برای مطالعه، زمان و مکان مناسبی را انتخاب کنید.
- مطالب را تمرین، تکرار و مرور کنید تا کاملا در ذهنتان تثبیت شوند.

همچنین کلید یادگیری زیست، انجام کلیه تکالیف و تفکر عمیق درباره موضوعات این کتاب است. باید فرآیندها و سیستمهای بیولوژیکی این درس را یاد بگیرید و بر مفاهیم کلی تسلط داشته باشید. اگر چه مطالعه کتاب درسی و کتب کمک آموزشی به یادگیری نظریههای زیست کمک میکند اما برای درک عمیقتر، بهتر است فرآیندهای بیولوژی را در آزمایشگاه، آزمایش کنید، با این کار دیگر مباحث را فراموش نخواهید کرد.
اگر دانشآموز پایده دهم و یازدهم باشید کار شما راحتتر است اما اگر پایه دوازدهم باشید کارتان کمی سخت و فشرده میشود زیرا علاوه بر مطالعه زیست شناسی پایه دوازدهم باید زیست سال دهم و یازدهم را هم بخوانید. برای یادگیری زیست دوازدهم، تسلط بر زیست پایههای دهم و یازدهم ضروری است. برای یادگیری بهتر مفاهیم میتوانید از درسنامههای کتب معتبر استفاده کنید و سپس به سراغ تستزدن بروید. بهتر است از تستهای راحت شروع کنید و در مرحله بعد تستهای کنکور و تستهای تالیفی سخت را مطالعه کنید. مرور و تکرار مباحث، رکن اصلی یادگیری بهتر و مطالعه مفید است، بنابراین حتما دروس را در هفته به تعداد دفعات زیاد مرور کنید تا مفاهیم را به طور کامل یاد بگیرید.
دقت داشته باشید که ساعات مطالعه کافی و مناسب در کنار مطالعه باکیفیت شانس موفقیت شما را در امتحانات نهایی و کنکور افزایش میدهد. در صورتی که از جدیدترین روشهای مطالعه زیست شناسی استفاده کرده و مطالعه باکیفیتی داشته باشید اما ساعات مطالعه شما کم باشد نتیجه دلخواهتان را به دست نمیآورید. زیست شناسی درسی پیچیده است و شما باید روزانه برای مطالعه آن زمان صرف کنید. توصیه میکنیم 25 درصد از مطالعه کل هفته خود را به این درس اختصاص داده و مطالعه تشریحی کتاب، درسنامه، تستزنی، مرور و فیلم را در برنامه خود بگنجانید. دانشآموزانی که در درس زیست شناسی ضعف دارند باید بیشتر از 25 درصد و کل هفته را به مطالعه این درس اختصاص دهند. البته ساعات مطالعه هر فرد بستگی به پایه درسی و سرعت مطالعه و یادگیری او دارد.
چگونه زیست را شب امتحان بخوانیم؟
با توجه به سخت و پیچیده بودن زیست شناسی توصیه میکنیم این درس را در طول سال بخوانید زیرا یادگیری زیست فقط در شب امتحان امکانپذیر نیست. اگر قصد دارید نمره کاملی در این درس بگیرید حتما با صرف زمان کافی، نکات و مباحث آن را با دقت و حوصله به خاطر بسپارید. زیست شناسی صرفا یک درس حفظ شدنی نیست و حفظ کردن طوطیوار مباحث این کتاب روش مناسبی برای مطالعه آن نمیباشد. باید با روش صحیح، این درس را به صورت عمیق و مفهومی یاد بگیرید. رعایت نکات زیر در شب امتحان زیست شناسی باعث میشود نمره بهتری در این درس بگیرید:
- در شب امتحان مطالب قبلی را مرور کنید و از یادگیری مباحث جدید بپرهیزید.
- سعی کنید با استفاده از فلش کارت و خلاصهبرداری مباحث را مرور کنید.
- برای یادگیری بهتر، نکات را در یک برگه یادداشت کنید.
- بین ساعات مطالعه استراحت کنید.
- در شب امتحان خواب کافی داشته باشید و تا صبح بیدار نمانید.
- نمونه سوالات سالهای قبل را بررسی کنید.
- با دوستانتان مباحث را به اشتراک بگذارید.
- استرس نداشته باشید تا علاوه بر یادگیری بهتر مطالب، در جلسه امتحان هم عملکرد خوبی داشته باشید.
چگونه زیست را سریع یاد بگیریم؟
دانشآموزان زیادی با صرف زمان کافی برای مطالعه زیست همچنان در یادگیری مباحث این درس مشکل دارند. این دسته از دانشآموزان فصلها را پشت سر هم میخوانند و پس از اتمام مباحث احساس میکنند هیچ چیزی یاد نگرفتهاند و تمامی مطالب را فراموش کردهاند.
مهمترین نکته در یادگیری سریع زیست شناسی، تکرار یک مبحث تا زمان یادگیری آن است. یعنی به جای این که بدون یادگیری عمیق یک فصل، آن را از ابتدا تا آخر بخوانید و به سراغ فصلهای بعد بروید تا زمانی که یک مبحث را یاد نگرفتهاید روی آن تمرکز کنید. برخی دانشآموزان فکر میکنند با تکرار یک بخش تا یادگیری کامل آن، دچار کمبود زمان شده و مطالعه آنها کند میشود در صورتی که این طور نیست.
روش صحیح مطالعه زیست یعنی مطالعه و تکرار یک بخش تا زمان یادگیری کامل و سپس رفتن به سراغ بخشهای بعدی؛ اگر فکر میکنید این کار زمانبر است برای یکبار آن را امتحان کنید. برای مثال یک جمله مربوط به گیاهی را بیشتر از ده بار تمرین کنید و همزمان وقت بگیرید. در نهایت میبینید این کار فقط 5 دقیقه زمان برده است. سعی کنید جملات را روی برگه یادداشت کنید تا در ذهنتان بماند. بنابراین اولین قانون سریع خواندن و درست خواندن درس زیست شناسی این است که تا زمانی که یک فصل یا بخش را یاد نگرفتهاید به سراغ بخش بعدی نروید. برای مطالعه بهینه درس زیست شناسی از تکنیکهای زیر کمک بگیرید:
- تمامی فصلها را یکبار به صورت کلی مطالعه کنید.
- فصل موردنظر را براساس تیترهای تستی بخوانید.
- سپس با دقت زیاد و با تکرار و تمرین، مطالب را بخوانید و به ذهن بسپارید.
- پس از مطالعه و یادگیری یک فصل، به سراغ درسنامه و کتاب تست رفته و آنها را بخوانید.
- در مرحله بعد تست بزنید و نکات مهم را یادداشت کنید.
- طبق مراحل بالا تمامی فصلها را بخوانید.
- یک روز بعد از خواندن فصل، دوباره به سراغ تستها رفته و تستهای مفهومی را حل کنید.
- بعد از یادگیری کامل مباحث و تستزنی، خلاصهنویسی کنید.
- در کلاس درس فعال باشید و از نکات تدریس معلم نتبرداری کنید.
- سوالات مختلف را حل کنید و بارها مطالب را تکرار کنید تا در ذهنتان تثبیت شوند.
چطور زیست را برای امتحان تشریحی بخوانیم؟
برای این که درس زیست شناسی را برای امتحان تشریحی بخوانید باید در زمان مطالعه، مباحث را درک کنید. به زبان سادهتر باید بدانید پاراگرف موردنظر به چه چیزی اشاره دارد و هدف از آن چیست؟ سعی کنید در زمان مطالعه سوالات مختلفی را درباره مطالب در ذهنتان طرح کرده و به آنها پاسخ دهید. اگر نتوانستید به سوالاتی که در ذهنتان دارید جواب بدهید آنها را یادداشت کرده و از معلم خود بپرسید. بهتر است با استفاده از روشهایی مانند هایلایت یا خط کشیدن، نکات و مطالب هر مبحث را علامتگذاری کنید. دیگر نکات مربوط به مطالعه امتحان تشریحی زیست شامل موارد زیر هستند:
- مرور مطالب مهم درس
- پیشخوانی فصل برای درک بهتر مفهوم اصلی آن
- توضیح مطالب برای خودتان پس از یادگیری کامل مفاهیم
- مطالعه دقیق مثالها و مسائل کتاب
- مطالعه تصاویر، نمودارها و جداول درس زیست شناسی
- حل کردن نمونه سوالات امتحان نهایی سالهای قبل، این کار علاوه بر یادگیری و تثبیت مطالب در ذهنتان، باعث میشود با شیوه طراحی سوالات امتحان نهایی هم آشنا شوید.
سخن پایانی
در این مقاله نحوه مطالعه درس زیست شناسی را توضیح دادیم. همانطور که گفته شد زیست یکی از مهمترین درسهای رشته تجربی بوده و تاثیر قابل توجهی در قبولی داوطلبان در کنکور دارد. بنابراین نحوه مطالعه و یادگیری این درس از اهمیت ویژهای برخودار است. دانشآموزان و داوطلبان کنکور باید وقت و دقت کافی برای خواندن درس زیست شناسی صرف کنند تا به نتیجه دلخواهشان در امتحانات نهایی و کنکور برسند.با توجه به ماهیت حفظی و مفهومی درس زیست شناسی توصیه میکنیم این درس به صورت ترکیبی خوانده شود. برای این کار میتوانید از روشها و نکات ارائه شده در مقاله کمک بگیرید.

هنوز دیدگاهی ارسال نشده است